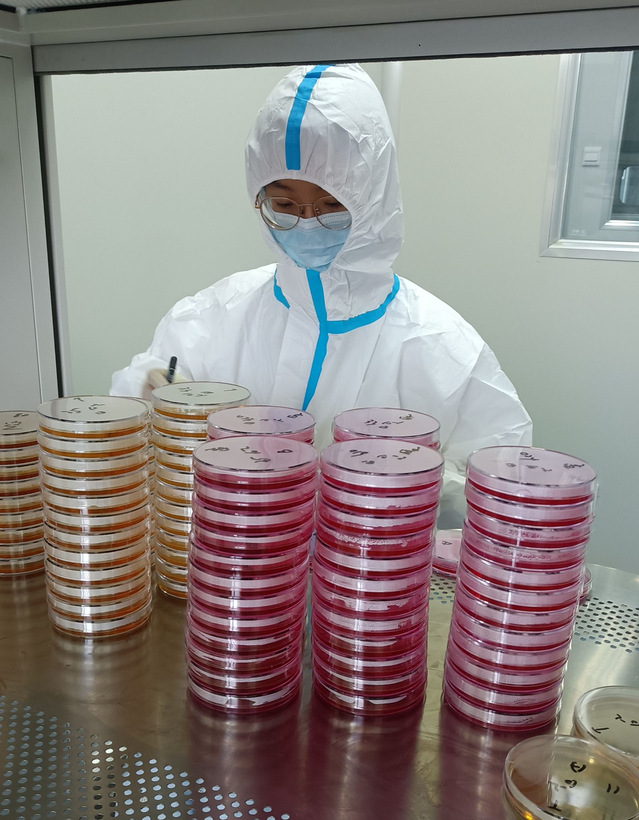

石河子大学食品学院“市监置前沿,合力博新天”发展成就观察社会实践团积极响应时代号召,走入图木舒克市,从7月5日开始进行为期15天的“三下乡”活动,以在食品药品检验所的学习为切入视角,了解其检测发展成就。
图木舒克食品药品检验所成立于2020年3月9日。食品药品检验所从原来基础上扩建到1000平方米,人员扩增到22人,其中三人为研究生。食药所积极响应人才引进计划,引进高端设备,提高技术服务水平,同时承担食品、药品、化妆品、粮油质量和医疗器械的检验检测工作 。
在医疗器械的检测工作中,成员学习先进仪器的使用;在微生物的实验中,成员制作培养基,检测化妆品等中微生物种类,在专业检测人员的带领中汲取经验;成员观察执法人员进行市场抽样的过程,学习样品检测的前处理全过程。
食药所将继续给广大食品学院学生提供理论学习和实践学习的平台,为图木舒克市食品药品检验所奠定人才基础。

通讯员:黎依洋、张静怡、李英豪

